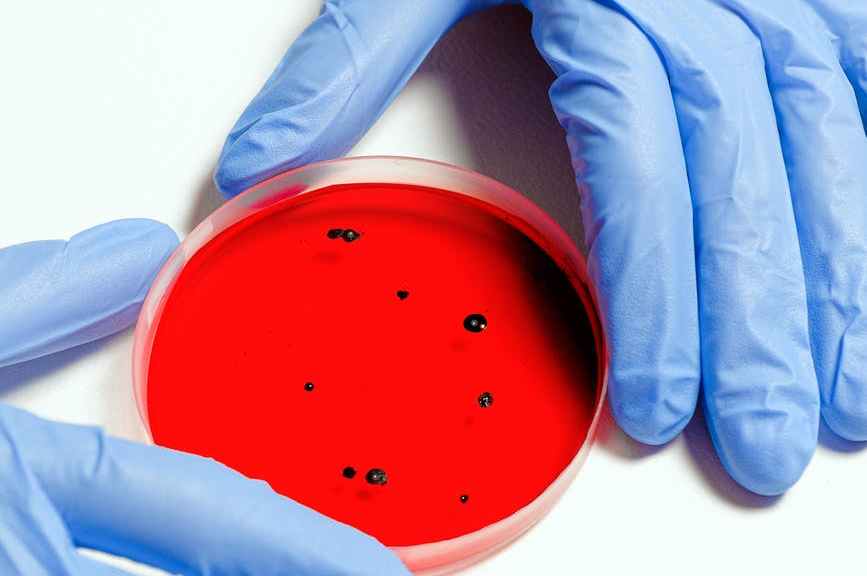

According to authorities, tear gas was deployed to disperse protesters outside the Arizona State Capitol. Numerous protestors gathered in New York City’s Washington Square Park to oppose the judgment. Anti-abortion protestors were there, although they maintained a low profile. Following the demonstration, at least 20 individuals were “taken into jail with charges pending” throughout the city. In 2019, the biggest proportion of abortions performed on women requesting the procedure were performed on black women.
According to the statistics, they also had the highest abortion rate, with 23,8 abortions per 1,000 women. Black women who are pregnant or have just given birth are three to four times more likely to die than White women in the same circumstances. Friday, after the Supreme Court reverses Roe v. Wade, anti-abortion groups protest in Washington, D.C. Champagne is consumed by anti-abortion activists in front of the Supreme Court. Rachel Herring, an anti-abortion campaigner, said, “According to Judaism, life starts with the first breath, when the soul enters the body.”
Following the Supreme Court’s decision to overturn Roe v. Wade, supporters for abortion rights pound on the doors of the Arizona State Senate. On Friday, June 24, anti-abortion demonstrators celebrate in front of the US Supreme Court in Washington, DC. An anti-abortion activist wears socks that proclaim “abortion is cruel” while arguing with an abortion rights activist. On Friday, Jill McElroy and her nine-year-old daughter Meriam joined in an abortion rights rally in front of the Supreme Court. She stated, “A lesson we have always taught our children is that they are the masters of their own bodies, and the Court’s ruling today goes against that, and as a family, we believe that’s wrong.”
Champagne is consumed by anti-abortion activists in front of the Supreme Court. I was there at the moment the decision was made. I am delighted. Earlier, I was walking on air, says pro-life activist Noah Slayter. Friday, the phrase “Our bodies, our choices” is spray-painted on a temporary wall in Washington, D.C.
Following the Supreme Court’s decision to overturn Roe v. Wade, pro-choice protestors pound on the doors of the Arizona State Senate on Friday. Outside the U.S. Supreme Court on Friday, an anti-abortion protester wears socks that proclaim “abortion is cruel.” In Arizona and Arkansas, abortion providers have began discontinuing their services. Dr. DeShawn Taylor remarked that she anticipates a period of darkness, albeit hopefully not for too long.
Approximately twenty abortion appointments originally planned for Friday through next week were canceled by Taylor’s facility. The head of Planned Parenthood said, “The majority of patients were desperate or scared” before to Friday’s Supreme Court ruling on abortion availability in certain states. A new legislation in California shields anybody conducting, helping, or receiving an abortion from any prospective civil action originating from outside the state. A clinic owner in Mississippi said that a woman should not have to leave the state to get medical treatment.